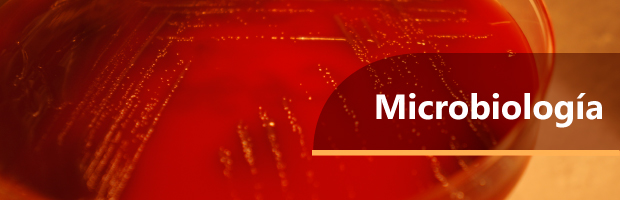

¿QUÉ HACEMOS?
El Grupo de microbiología en un laboratorio que orienta y apoya en la detección, caracterización, seguimiento e investigación de agentes bacterianos y micoticos de interés en la salud pública mediante el fortalecimiento de la vigilancia por laboratorio, la caracterización fenotípica y molecular, realización de evaluaciones externas del desempeño, la elaboración de lineamientos técnicos, realización de asistencias técnicas, transferencia tecnológica y desarrollo de proyectos de investigación.
¿CÓMO LO HACEMOS?
Realizamos la caracterización fenotípica y molecular de agentes bacterianos recuperados bajo el marco de la de vigilancia por laboratorio de las infecciones bacterianas y micóticas de importancia en salud pública, como infección respiratoria aguda, meningitis bacteriana aguda, enfermedad diarreica aguda, enfermedad transmitida por alimentos, infección transmitida sexualmente, síndromes febriles como leptospirosis, rickettsiosis, brucelosis y micosis sistémicas. Además se desarrollan evaluaciones externas del desempeño directa e indirectas y participamos en las evaluaciones del desempeño internacionales en las pruebas diagnósticas para las infecciones bacterianas de importancia en salud pública.
También estandarizamos y validamos ensayos diagnósticos clásicos y moleculares con el fin de mejorar la vigilancia por laboratorio, desarrollamos propuestas de investigación aplicada a nivel nacional e internacional y asesoramos a los laboratorios departamentales de salud pública, estudiantes de pregrado, postgrado y al Ministerio de Salud y Protección Social en la formulación de políticas, normas y directrices relacionadas con la vigilancia por el laboratorio de eventos de interés en salud pública.
Consulta
